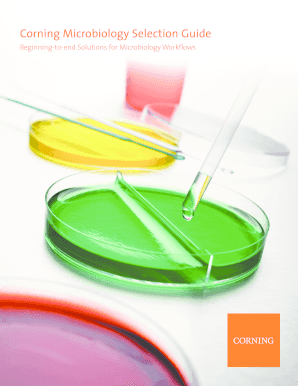

Get the free Employee Enrollment Form - CalCPA Health
Show details
Employee Enrollment Form To be completed by each employee becoming a member of a medical, dental or vision plan, applying for COBRA coverage, or waiving coverage. Type of Enrollment (New Enrollment,
We are not affiliated with any brand or entity on this form
Get, Create, Make and Sign employee enrollment form

Edit your employee enrollment form form online
Type text, complete fillable fields, insert images, highlight or blackout data for discretion, add comments, and more.

Add your legally-binding signature
Draw or type your signature, upload a signature image, or capture it with your digital camera.

Share your form instantly
Email, fax, or share your employee enrollment form form via URL. You can also download, print, or export forms to your preferred cloud storage service.
How to edit employee enrollment form online
Here are the steps you need to follow to get started with our professional PDF editor:
1
Register the account. Begin by clicking Start Free Trial and create a profile if you are a new user.
2
Simply add a document. Select Add New from your Dashboard and import a file into the system by uploading it from your device or importing it via the cloud, online, or internal mail. Then click Begin editing.
3
Edit employee enrollment form. Replace text, adding objects, rearranging pages, and more. Then select the Documents tab to combine, divide, lock or unlock the file.
4
Save your file. Select it from your records list. Then, click the right toolbar and select one of the various exporting options: save in numerous formats, download as PDF, email, or cloud.
It's easier to work with documents with pdfFiller than you can have ever thought. Sign up for a free account to view.
Uncompromising security for your PDF editing and eSignature needs
Your private information is safe with pdfFiller. We employ end-to-end encryption, secure cloud storage, and advanced access control to protect your documents and maintain regulatory compliance.
How to fill out employee enrollment form

How to fill out employee enrollment form
01
Obtain the employee enrollment form from the HR department or download it from the company's website.
02
Read through the instructions on the form to understand the information required.
03
Fill in the employee's personal details such as full name, date of birth, address, and contact information.
04
Provide information about the employee's employment status, including job title, department, and start date.
05
Include information about the employee's dependents if applicable, such as their names and dates of birth.
06
Fill out the sections related to the employee's benefits preferences, such as health insurance, retirement plans, and vacation time.
07
If necessary, complete any additional sections or provide any required documentation as specified on the form.
08
Review the completed form for accuracy and make any necessary corrections before submitting it.
09
Sign and date the employee enrollment form to certify that the information provided is true and accurate.
10
Submit the filled-out form to the HR department or follow the instructions provided on where to send it.
Who needs employee enrollment form?
01
The employee enrollment form is needed by new employees joining a company.
02
Existing employees may also need to fill out an updated version of the form when making changes to their benefits or personal information.
03
The HR department or the relevant personnel responsible for employee records and benefits administration would require this form for documentation and record-keeping purposes.
Fill
form
: Try Risk Free






For pdfFiller’s FAQs
Below is a list of the most common customer questions. If you can’t find an answer to your question, please don’t hesitate to reach out to us.
How can I get employee enrollment form?
With pdfFiller, an all-in-one online tool for professional document management, it's easy to fill out documents. Over 25 million fillable forms are available on our website, and you can find the employee enrollment form in a matter of seconds. Open it right away and start making it your own with help from advanced editing tools.
How do I fill out employee enrollment form using my mobile device?
You can quickly make and fill out legal forms with the help of the pdfFiller app on your phone. Complete and sign employee enrollment form and other documents on your mobile device using the application. If you want to learn more about how the PDF editor works, go to pdfFiller.com.
How do I edit employee enrollment form on an Android device?
You can edit, sign, and distribute employee enrollment form on your mobile device from anywhere using the pdfFiller mobile app for Android; all you need is an internet connection. Download the app and begin streamlining your document workflow from anywhere.
What is employee enrollment form?
Employee enrollment form is a document used to gather information about a new employee, such as their personal details, contact information, and employment history.
Who is required to file employee enrollment form?
Employers are required to file employee enrollment forms for all new employees.
How to fill out employee enrollment form?
Employee enrollment forms can be filled out either electronically or manually, and typically require information such as name, address, date of birth, and social security number.
What is the purpose of employee enrollment form?
The purpose of employee enrollment form is to collect necessary information about a new employee for payroll, benefits, and tax purposes.
What information must be reported on employee enrollment form?
Employee enrollment form typically requires information such as name, address, contact information, social security number, date of birth, and employment history.
Fill out your employee enrollment form online with pdfFiller!
pdfFiller is an end-to-end solution for managing, creating, and editing documents and forms in the cloud. Save time and hassle by preparing your tax forms online.

Employee Enrollment Form is not the form you're looking for?Search for another form here.
Relevant keywords
Related Forms
If you believe that this page should be taken down, please follow our DMCA take down process
here
.
This form may include fields for payment information. Data entered in these fields is not covered by PCI DSS compliance.